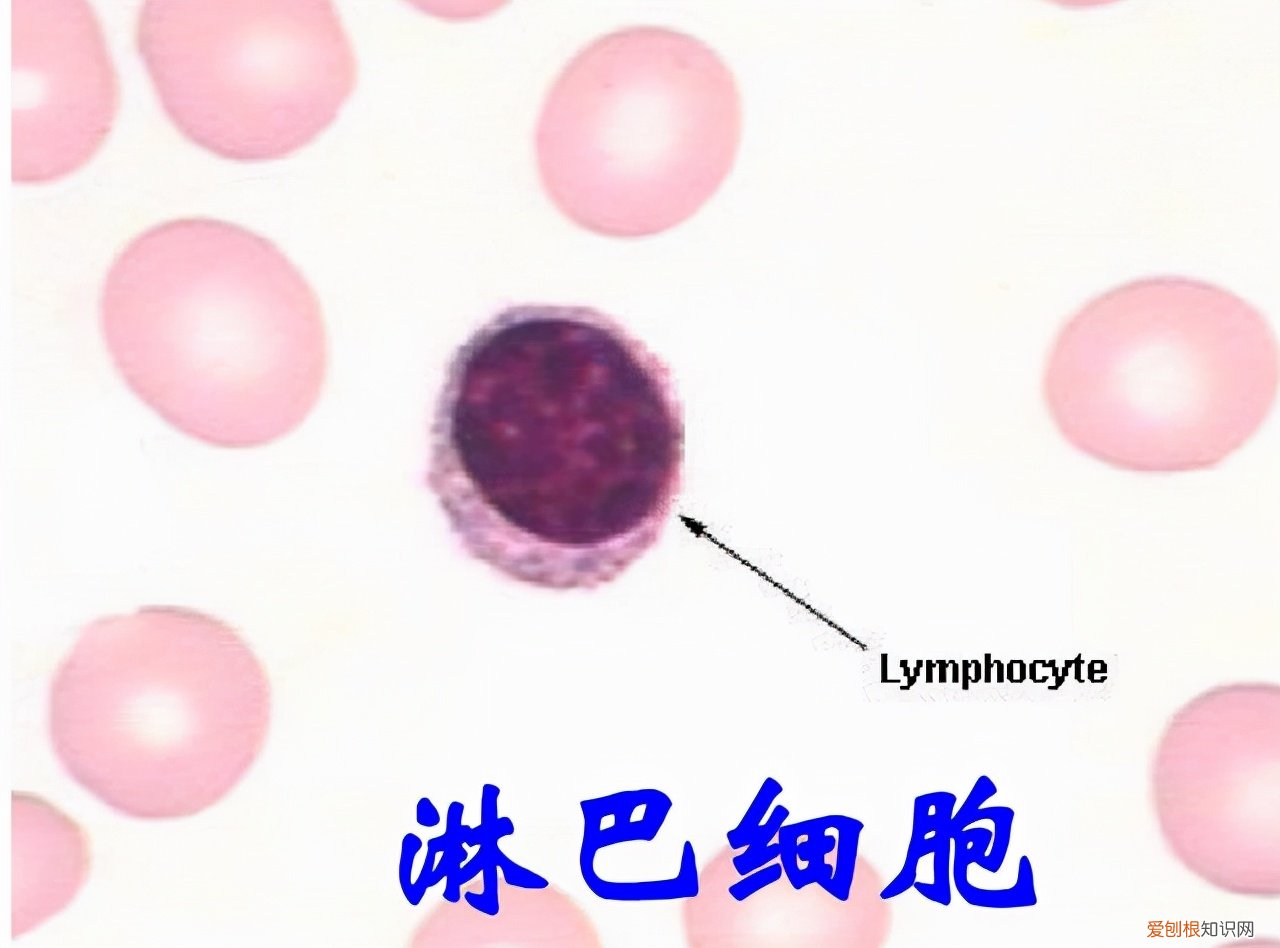
淋巴细胞百分比偏高一点点要紧吗？看看专家怎么说

文章插图
体检不到位,亲人两行泪!随着国民生活水平的提高,人们渐渐意识到了养生保健的重要性,为了更好的养护身体健康,多数公民会自行体检检测,尽早发现身上的小毛病,尽早治愈,避免不良恶性疾病的发生 。

文章插图

文章插图
在众多体检项目中,血常规检查绝对是最常见也是最基础的检测方式之一,对常规检查主要是指通过直接采血的方式,进行体检检测,帮助患者明确身体健康状况,确定病变情况 。
血常规检查项目包括:红细胞、血小板、白细胞、血红蛋白、中性粒细胞、单核细胞、淋巴细胞等多项血象分析,通过红细胞和血红蛋白的数量可以清晰的判断一个人是否贫血,学功能是否出现异常?通过白细胞可以判断患者体内是否有炎症存在 。

文章插图

文章插图
很多人拿到血常规体检检查单时,经常会发现体检单上会有很多异常的上升、下降箭头,多数人对此一脸懵,不知道到底是什么意思,下面就带大家一起来了解一下,一旦发现血常规检查中的这三个数值异常升高,一定要做进一步检查 。
01
血常规检查中,如果这3个指标升高,建议做进一步检查
【淋巴细胞数值升高】
每个人的身体中都有淋巴细胞的存在,淋巴细胞的主要作用是:抵御疾病感染、抵御肿瘤、产生抗体,杀死靶向细胞 。
淋巴细胞分为T淋巴细胞、B淋巴细胞,淋巴细胞是白细胞中数量最小的一种,主要存在于淋巴管循环的淋巴液中,是构成机体免疫应答的重要组成成分 。

文章插图

文章插图
淋巴细胞的正常范围是0.8-4.0×10^9/L,淋巴细胞比率正常值是20-40%,淋巴细胞升高常见于以下2种疾病:
1、淋巴细胞白血病
当患者出现淋巴细胞白血病或局部造血功能异常时,就会导致淋巴细胞明显升高,这类疾病需要做骨髓穿刺,进一步明确检查,确定病灶部位 。
2、病毒感染
流行性病毒感染、流行性感冒发烧、病毒性肺炎、手足口病,都会导致淋巴细胞异常升高 。
文章插图

文章插图
【红细胞数值升高】
红细胞是人体中最多的血细胞,红细胞的主要作用是输送氧气,运输二氧化碳,红细胞中含有大量的血红蛋白参与氧气结合,将氧气运输至身体各个器官,一旦红细胞缺乏,也会影响人体正常呼吸和循环的能力,导致机体缺氧诱发贫血症状 。
红细胞的正常参考范围是
新生儿:(6.0~7.0)×10^12/L
婴儿:(5.2~7.0)×10^12/L
儿童:(4.2~5.2)×10^12/L
成人男性:(4.0~5.5)×10^12/L
成人女性:(3.5~5.0)×10^12/L
红细胞异常升高常与以下两点原因有关:
1、病理性红细胞增多
常见于频繁呕吐、大面积烧伤、慢性肺气肿、肺心病、高原病、肿瘤等恶性疾病 。
2、生理性红细胞增多
多见于精神因素(剧烈、兴奋、刺激、恐慌可导致肾上腺素异常升高,也会诱发红细胞升高),妊娠期在孕激素的影响下,也会导致身体红细胞升高 。
推荐阅读
- 富士山是私人的吗?日本的富士山属于私人所有
- 大熊猫为什么爱吃竹子,熊猫吃肉吗?
- 鸵鸟如何躲避危险 鸵鸟为什么把头埋进沙子里
- 中国最宽的瀑布排名 中国最宽的瀑布在哪里
- 4块5的爱情含义 四块五的妞意思
- 萤火虫发光原理介绍 萤火虫为什么会发光
- 四大洋哪个最可怕 四大洋面积最小的是哪一个
- 信鸽不会迷路的原因 信鸽为什么不会迷路
- 孔雀开屏的寓意介绍 孔雀为什么要开屏
